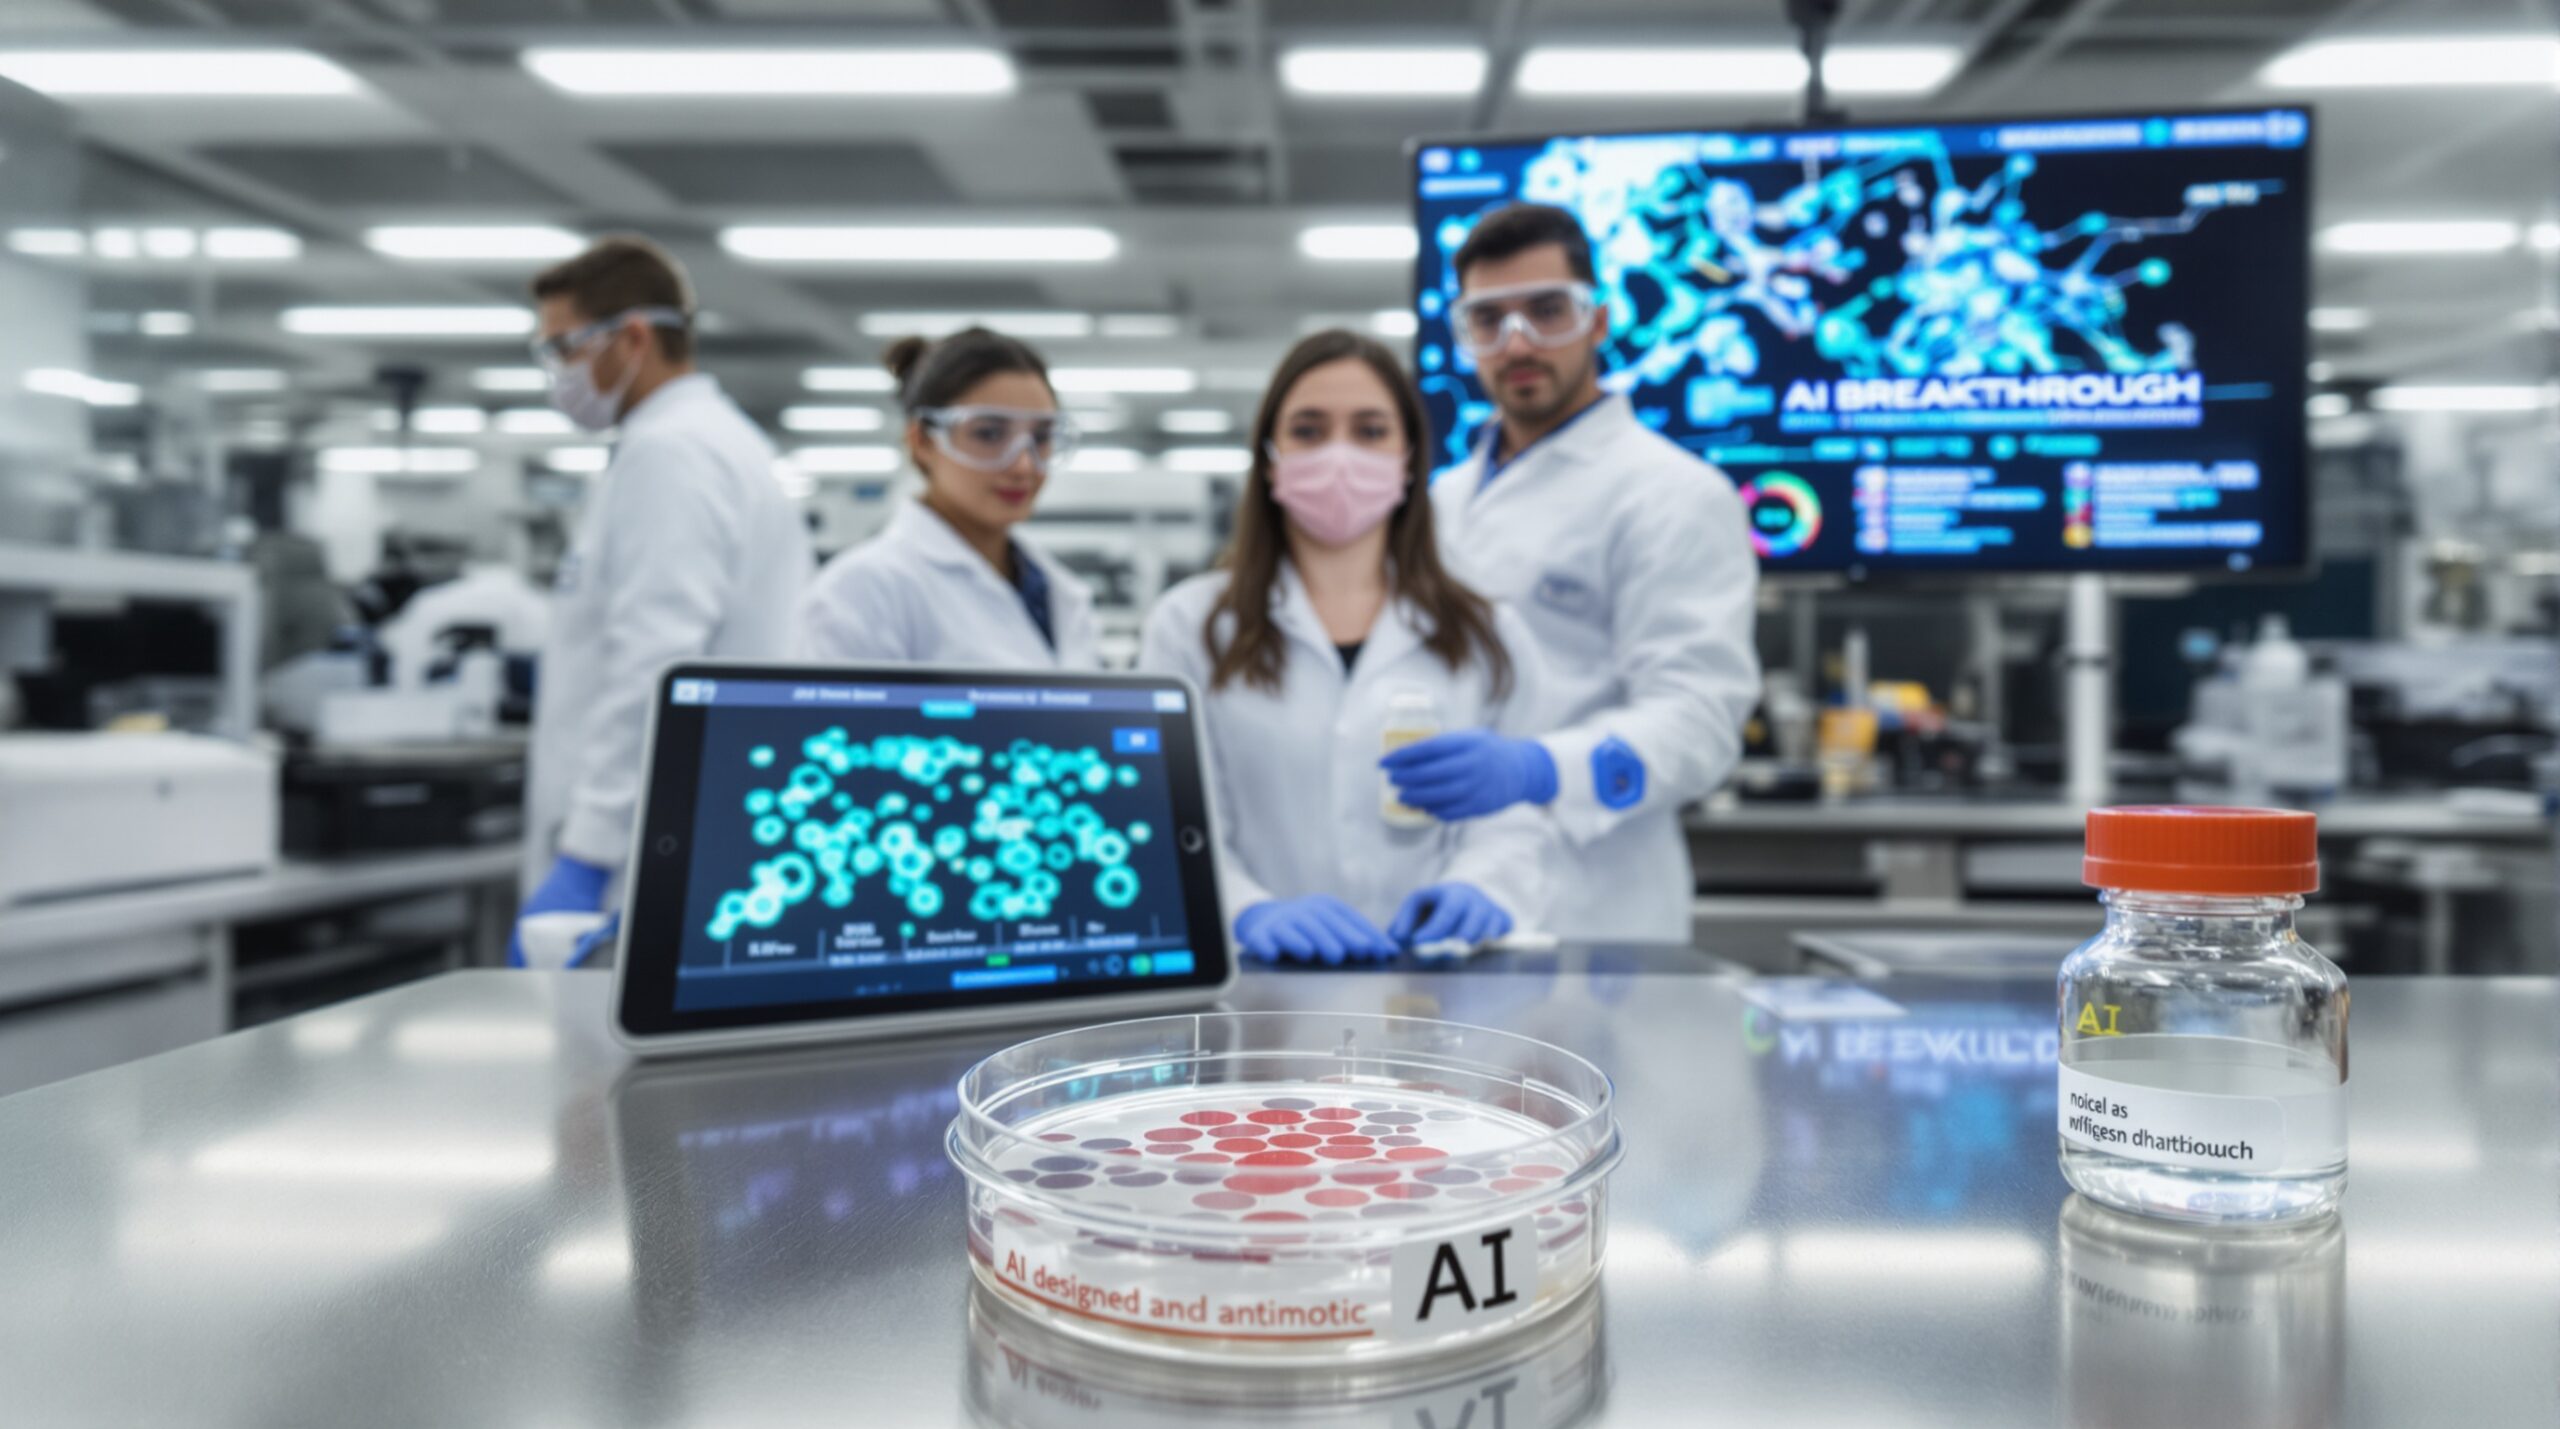

Scientists have unveiled an AI-designed antibiotic with strong activity against drug-resistant superbugs. The advance expands our arsenal against worsening antimicrobial resistance. Early data highlight broad potency, selective targeting, and a promising safety profile in preclinical tests. Algorithms accelerated discovery by narrowing billions of chemical possibilities. Researchers then validated top candidates through rigorous laboratory and animal studies. Together, these steps open a new front in the fight against superbugs.
Why this breakthrough matters now
Antimicrobial resistance threatens modern medicine and global health security. Resistant infections already cause hundreds of thousands of deaths yearly. A landmark analysis estimated 1.27 million deaths attributable to resistant bacteria in 2019. Many more deaths occurred where resistance contributed to poor outcomes. Meanwhile, the antibiotic pipeline remains thin for priority Gram-negative pathogens. Therefore, new discovery approaches carry urgent importance for patients and health systems.
How artificial intelligence designed the candidate
Researchers trained models on compound structures and antibacterial activity data. The models learned features linked to potency, selectivity, and permeability. They also incorporated toxicity, solubility, and metabolic stability constraints. Generative algorithms proposed new scaffolds beyond traditional libraries. A second model filtered designs using multi-objective optimization. Finally, chemists synthesized top candidates for immediate biological testing.
Learning from precedent successes
Prior work validated the approach using related strategies. A deep-learning screen previously identified halicin, which killed resistant Acinetobacter in mice. Another effort uncovered abaucin, which selectively targets Acinetobacter baumannii. These studies combined computational models with systematic wet-lab assays. They demonstrated how AI can find nontraditional antibiotic chemistries. The new candidate builds on those lessons and workflows.
What the experiments reveal
Laboratory assays showed low minimum inhibitory concentrations against difficult Gram-negative pathogens. Activity extended to carbapenem-resistant Acinetobacter, Pseudomonas, and Klebsiella strains. The compound also suppressed methicillin-resistant Staphylococcus aureus in some assays. Time-kill studies indicated rapid bactericidal effects at achievable concentrations. Biofilm models showed meaningful biomass reduction and viability loss. These findings justify continued translational development and expanded testing.
Evidence from animal infection models
Investigators evaluated efficacy in standard mouse infection models. Treatment reduced bacterial loads and improved survival in acute infections. Dose-response relationships supported favorable pharmacodynamic profiles. Preliminary data suggested synergy with select beta-lactams. Pharmacokinetic studies showed exposures exceeding target levels in plasma. Importantly, animals tolerated efficacious doses without clear toxicity signals.
Indications of a novel mechanism
Mechanistic studies provided early insights. Membrane potential assays suggested possible disruption of bacterial energy gradients. Alternative analyses indicated interference with lipoprotein trafficking pathways. Such pathways are essential for Gram-negative outer membrane biogenesis. Genetic and biochemical follow-ups are now clarifying the primary target. A novel mechanism could slow resistance development and avoid cross-resistance.
Why novelty helps resist resistance
Resistance often spreads through shared target classes and efflux systems. Compounds acting on new targets face fewer existing defenses. Fitness costs can further slow resistance emergence. AI can prioritize scaffolds that evade efflux pumps and permeability barriers. It can also optimize physicochemical properties for Gram-negative penetration. These advantages support durable clinical utility if validated.
Safety, selectivity, and microbiome considerations
Safety profiles guide every development stage. Researchers screened the compound across human cell lines for cytotoxicity. Assays evaluated mitochondrial toxicity, lysosomal stress, and membrane integrity. Early results indicated acceptable selectivity over mammalian cells. Additional studies measured cardiac ion channel interactions, including hERG. Microbiome panels assessed off-target impacts on commensal bacteria.
The team observed limited disruption of key gut commensals in vitro. Narrower collateral damage could reduce dysbiosis and downstream complications. However, comprehensive microbiome effects require careful clinical evaluation. Animal studies will measure colonization resistance and Clostridioides difficile risks. Translational teams will integrate these data into benefit-risk assessments. That process ensures patient safety remains paramount throughout development.
From algorithm to clinic: the development pathway
Moving from hits to humans requires disciplined execution. Chemists will optimize the scaffold for potency, solubility, and stability. Pharmacologists will define exposure-response relationships using PK/PD modeling. Toxicologists will run dose-range and repeat-dose studies in two species. Manufacturers will scale synthesis under quality guidelines for clinical supply. Regulators will review an Investigational New Drug application before trials.
Phase I studies will evaluate safety, tolerability, and pharmacokinetics in healthy volunteers. Food effects and drug-drug interactions will receive attention. Phase II trials will test efficacy in defined infection syndromes. Designs may include complicated urinary or intra-abdominal infections. Microbiological endpoints will complement clinical outcomes. Adaptive designs could accelerate dose selection under stewardship principles.
Comparing AI-driven discovery with traditional methods
Traditional discovery explores chemical space slowly and expensively. AI accelerates exploration while filtering compounds with poor properties. It also generates hypotheses about mechanisms and resistance pathways. However, algorithms can overfit and miss critical liabilities. Robust wet-lab validation remains essential at every stage. Transparent datasets and benchmarks help improve models and trust.
Data quality drives model performance
High-quality, diverse datasets reduce bias and improve generalization. Curated activity measurements enable reliable structure-activity learning. Negative data are as important as positive hits. Standardized assays support cross-study comparability and reproducibility. Open data collaborations can expand coverage across pathogens and chemotypes. These practices strengthen the scientific basis for AI predictions.
Managing resistance through stewardship and combinations
Even breakthrough antibiotics require careful stewardship. Researchers monitor resistance emergence using serial passage experiments. They map mutations and fitness costs to refine use strategies. Clinicians can deploy combinations to suppress resistance trajectories. Diagnostics can guide targeted use and preserve effectiveness. Stewardship protects patients while sustaining the antibiotic’s long-term value.
Rapid diagnostics enable targeted therapy
Point-of-care tests can identify pathogens and resistance markers quickly. Rapid results support earlier effective therapy and shorter courses. AI-designed antibiotics fit well with test-and-treat pathways. Laboratories can integrate susceptibility testing into clinical algorithms. Health systems should pair deployment with surveillance networks. Continuous data will refine dosing and indications over time.
Financing, incentives, and equitable access
Economic incentives remain essential for antibiotic innovation. Subscription payment models can reward value without driving overuse. Proposed pull incentives aim to secure predictable returns for developers. These include transferable exclusivity vouchers and delinked contracts. Policymakers also prioritize global access and affordable pricing. Partnerships can ensure availability in low- and middle-income countries.
Manufacturing plans should include regional production where feasible. Technology transfer can build sustainable supply capacity. Equitable access strengthens pandemic preparedness and health security. Transparent licensing can balance returns with public health goals. Donors and development banks can support procurement and distribution. Together, these steps translate scientific gains into societal benefits.
What comes next for this AI-designed antibiotic
The team will broaden pathogen panels and resistance challenges. They will explore dosing strategies that maximize exposure and minimize toxicity. Further mechanistic studies will confirm the primary target. Medicinal chemistry will refine properties for oral or intravenous use. Clinical development plans will prioritize urgent unmet needs. External advisors will review data and guide trial design.
Independent replication will strengthen confidence before late-stage trials. Meanwhile, stewardship frameworks can prepare for responsible deployment. Regulatory agencies encourage early communication and adaptive approaches. Health systems can plan for diagnostic integration and data capture. Global partners can align access, manufacturing, and surveillance strategies. These efforts can accelerate safe, equitable delivery to patients.
Outlook: a new front against antimicrobial resistance
This advance shows how AI can revitalize antibiotic discovery. It complements proven scientific methods with speed and breadth. Real-world impact will depend on rigorous testing and careful stewardship. Transparent evidence will build clinician and patient trust. Equitable access will ensure benefits reach those most at risk. With sustained collaboration, this breakthrough could reshape the fight against superbugs.